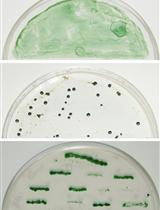
蓝藻菌鱼腥藻属物种 PCC 7120中的靶标基因失活

往期刊物2016
卷册: 6, 期号: 15
生物化学
Quantification of Chitinase Activity in Fusarium oxysporum
尖孢镰刀菌中几丁质酶活性的定量检测
Analytical Gel Filtration for Probing Heavy Metal Transfer between Proteins
凝胶过滤分析蛋白质之间重金属转移
细胞生物学
Mouse Liver Mitochondria Isolation, Size Fractionation, and Real-time MOMP Measurement
小鼠肝脏线粒体分离、大小分级和实时外膜通透性(MOMP)测量
Cell Tracer Violet and CellTracker Red CMTPX Staining of Purified Mature Plasmodium-infected Red Blood Cells
对疟原虫感染的红细胞进行示踪染色以观察免疫吞噬效应
A Live-imaging, Heat Shock-inducible System to Measure Aux/IAA Degradation Rates in Planta
活体成像的热激诱导系统测定植株的Aux/IAA降解率
免疫学
In vivo DCs Depletion with Diphtheria Toxin and MARCO+/MOMA1+ Cells Depletion with Clodronate Liposomes in B6.CD11c-DTR Mice
在B6.CD11c-DTR小鼠中使用白喉毒素和氯膦酸钠脂质体去除树突细胞及MARCO+/MOMA1+细胞
微生物学
A Highly Efficient Method for Measuring Oxygen Consumption Rate in Fusarium graminearum
禾谷镰刀菌中耗氧率的高效测量法
Antifungal and Zearalenone Inhibitory Activity of Ocimum sanctum L. Essential Oil on Fusarium graminearum Determined by UHPLC and RT-qPCR
采用UHPLC和RT-qPCR技术在禾谷镰刀菌上测定罗勒属精油的抗真菌和玉米烯酮抑制活性
分子生物学
Generation of IgG-Fc Glycovariants Using Recombinant Glycosidases and Glycosyltransferases
采用重组糖苷酶和糖基转移酶改变IgG-Fc糖基化修饰状态
Target Gene Inactivation in Cyanobacterium Anabaena sp. PCC 7120
蓝藻菌鱼腥藻属物种 PCC 7120中的靶标基因失活
Capillary Electrophoresis in Hydroxyethylcellulose Solutions for the Analysis of dsDNA, dsRNA, and siRNA
毛细管电泳法分析羟乙基纤维素溶液中的dsDNA、 dsRNA 和 siRNA
神经科学
Acute Live/Dead Assay for the Analysis of Toxic Effects of Drugs on Cultured Neurons
急性存活/死亡实验分析药物对培养神经元的毒性作用
植物科学
EST-SSR Analysis and Cross-species Transferability Study in Lavandula
熏衣草属的EST-SSR 分析和跨物种转移的研究
干细胞
Neurosphere Co-culture Assay
神经球共培养试验
Bone Marrow Mesenchymal Stem Cells Adhesion Assay
骨髓间充质干细胞粘附性测定